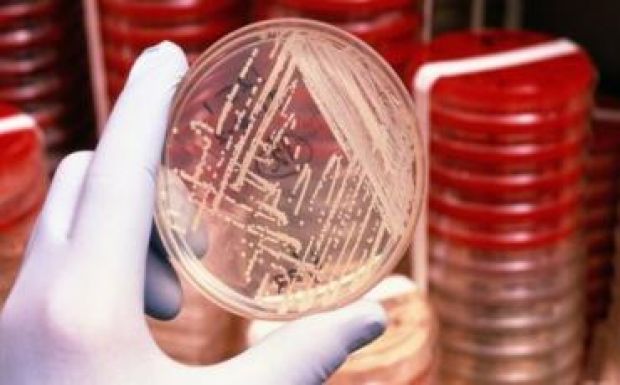

Először írtak le új baktériumfajokat Erdélyből
A Sapientia Erdélyi Magyar Tudományegyetem (EMTE) mikrobiólógusai együttműködve a budapesti Eötvös Loránd Tudományegyetem (ELTE) és a gödöllői Szent István Egyetem (SZIE) kutatóival elsőként írtak le Erdélyből a tudományra nézve két új baktériumfajt, amelyek a Medve-tóból illetve a cekendi hulladéklerakó csurgalékvizéből származnak.
A Sapientia Erdélyi Magyar Tudományegyetem csíkszeredai Biomérnöki Tanszékén zajló mikrobiológiai kutatások során környezetmérnök szakos hallgatók a tudomány számára eddig ismeretlen két új baktériumfajt tenyésztettek ki és azonosítottak DNS vizsgálatok alapján, dr. Máthé István oktató vezetésével. Az új fajokat leíró tanulmányhoz szükséges széleskörű biokémiai, molekuláris biológiai vizsgálatokat Dr. Felföldi Tamás (ELTE - Budapest) és Dr. Táncsics András (SZIE – Gödöllő) mikrobiológusok irányították. Mindkét baktériumfajt nemzetközi törzsgyűjteményekbe helyezték el, így az érdeklődő kutatók számára hozzáférhetők.
Az egyik baktériumfajt a szovátai Medve-tóból izolálták és a Rhodococcus sovatensis latin nevet kapta, ahol a kutatók által adott „sovatensis” név a származási helyre, azaz Szovátára utal. A másik fajt, a Rufibacter quisquiliarum a cekendi hulladéklerakó csurgalékvizéből tenyésztettük ki, a „quisquiliarum” latinul annyit jelent, hogy „hulladékból származó”.
A Rhodococcus nemzetség 58 fajt számlál, amelyek széles körben elterjedtek a környezetben (talaj, víz) és nagyon sokféle szerves anyagot képesek lebontani. Így egyes képviselőiket gyakran használják a környezeti biotechnológiában szénhidrogénekkel, így például kőolajszármazékokkal szennyezett talajok, talajvizek megtisztítására vagy üzemanyagok biológiai úton történő kénmentesítésére. Az eddigi vizsgálatok alapján elmondható, hogy a baktériumtörzsünk rendelkezik egyes szénhidrogének bontásához szükséges enzimkészlettel, és tervezik folytatni a baktérium kármentesítésben történő felhasználhatóságának a vizsgálatát.
A Rufibacter nemzetséget 2012-ben fedezték fel, jelenleg 7 faj tartozik ide, többségük talajból származik. Karotenoid típusú pigmenteket tartalmaznak, és egyes fajokról kimutatták, hogy jó ellenálló képességgel rendelkeznek UV- és radioaktív sugárzással szemben. A kutatók által izolált törzs jó szénhidrát, fehérje és zsírbontó képességgel rendelkezik, így szerepet játszik a csurgalékvíz tisztításában.
Világszerte mintegy 12000 baktériumfajt tartanak számon, de a szakemberek úgy vélik, hogy a Földünkön élő baktériumok döntő többsége (99%-a) jelenleg ismeretlen (azaz több mint egymillió „faj”), és csupán „genetikai ujjlenyomataik” alapján sejtjük ezeknek a mikrobáknak a létezését. Egy baktériumfajt akkor lehet leírni, behatóbban tanulmányozni, ha sikerül laboratóriumi tenyészetben szaporítani. A gyakorló mikrobiológusok egyik legnagyobb problémája, hogy a baktériumok nagy részét nem sikerül laboratóriumban, ún. táptalajokon szaporítani, nehéz „lemásolni” a természetes élőhelyükön uralkodó körülményeket.
Erdélyi különleges vizes élőhelyek mikrobiális sokszínűségének kutatása során egyedi táptalajokat fejlesztettek és Romániában először alkalmazták a „baktériumcsapdázásnak” is nevezett innovatív tenyésztési technikát. Ennek a lényege, hogy egy szilárd hordozót – a porózusos poliuretán (PUR)-habot – egyedi táptalajjal itatják át, majd belelógatják a vizsgált vízi élőhelybe és több hétig ott tartják. Ezen idő alatt egyes mikrobák elszaporodhatnak, majd utána ezeket behozzuk a laboratóriumba és minél több baktériumot próbálnak tiszta tenyészetbe vonni.
Az elmúlt 8 évben körülbelül 700 baktériumtörzset izoláltak a Sapientia EMTE csíkszeredai mikrobiológiai laboratóriumában, amelyek közül mintegy 20 új baktériumfaj jelölt. Párhuzamosan több új baktériumfaj tanulmányozása elkezdődött, a mai napig a fent említett két baktériumfajt sikerült leírni és az elkészült tanulmányokat nemzetközi szakmai folyóiratokban leközölni. Ezek az első új baktériumfajok, amelyeket Erdélyből írtak le. Korábban Romániából 3 új baktériumfaj került leírásra: egy faj (Haloferax prahovense) a Prahova megyei Telega-tóból, míg a másik kettő (Methanobacterium movilense, Methanosarcina spelaei) a Konstanca megyei Movile-barlangból származik.

.jpg)
.jpg)













